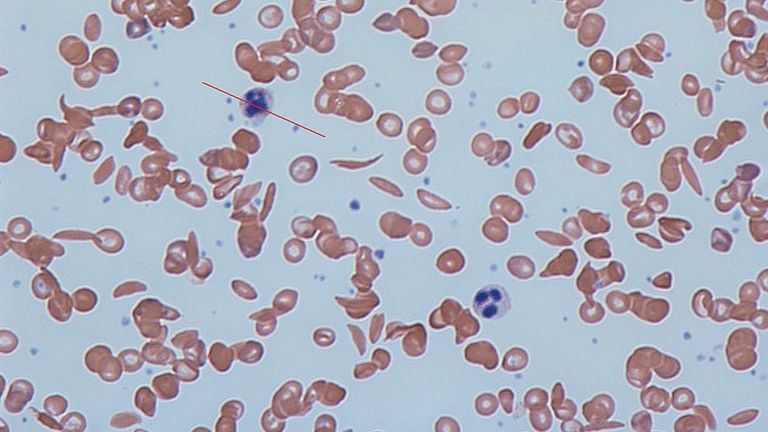

Health
New sickle cell disease treatment made available in UK
Thousands of people living in the UK could see their lives transformed by the drug Voxelotor.
Around 4,000 people living with the potentially fatal blood disorder could see their lives transformed by the drug Voxelotor.
Hazel Attua, 33, has been taking the medication for nearly two years. The former finance worker said the chronic pain forced her to quit her career.
She said: “One of the most significant changes I’ve experienced is in my energy levels. Previously, the exhaustion from sickle cell made it challenging to function, impacting my ability to work and enjoy time with loved ones. I wasn’t living the life of a 20-something by any means.
“Since starting Voxelotor, my energy has soared, making a massive change to my daily routine. This has not only improved my physical well-being but also my mental health.”
Sickle cell disorder causes red blood cells to take on a “sickle” shape, break and die early, which vastly reduces the amount of oxygen they can carry.
It leaves those affected with chronic anaemia and episodes of crippling pain, called crises, which can be life-threatening and frequently require hospital care.
The drug works by helping haemoglobin – a protein in red blood cells – hold on to more oxygen and prevent red blood cells from becoming misshapen.
It was initially rejected for widespread NHS use but the National Institute for Health and Care Excellence (NICE) has approved the drug in final draft guidance after a reduction in its price.
“We look forward to this being the first in a series of new treatment options for people living with sickle cell disorder.”
Helen Knight, director of medicines evaluation at NICE, said: “This is great news for people with sickle cell disease, particularly given the health inequalities experienced by people with the condition.”
The drug, which is taken as a once-a-day tablet, will be available straight away.

Health
Japa: Nigeria needs 300,000 doctors but has only 40,000

In 2024, the Minister of Health and Social Welfare, Prof. Muhammad Pate, revealed that Nigeria had about 55,000 licensed doctors.
Speaking during an interview on Channels TV’s Politics Today, Pate disclosed that no fewer than 16,000 doctors had left the country in the past five years, while about 17,000 others had been transferred out of active service.
Worrisomely, a new revelation by the Lagos State Commissioner for Health, Prof. Akin Abayomi, indicates that the number of practising doctors in Nigeria has declined from 55,000 to 40,000 within just one year.
In his presentation at a one-day leadership dialogue in Lagos themed “Strengthening PHC Systems: A Joint Leadership Dialogue,” Abayomi identified manpower shortage as one of the most critical challenges facing the health sector.
The dialogue, organised by the Lagos State Primary Health Care Board with support from development partners, addressed barriers hindering PHCs from meeting expectations and proposed practical solutions for building sustainable PHCs with lasting impact.
Abayomi stated that Lagos currently has only 7,000 doctors serving an estimated 30 million residents, far below the number needed for optimal care delivery.
The commissioner raised concerns over the acute shortage of health workers in the state, disclosing that the state requires an additional 33,000 doctors to meet the healthcare demands of its growing population.
“Nigeria currently has about 40,000 doctors against an estimated need of 300,000, while Lagos alone requires about 33,000 doctors but has only about 7,000,” he said.
According to him, Lagos’ doctor-to-population ratio remains far below what is required for optimal healthcare delivery, noting that the state’s doctors are serving an estimated population of nearly 30 million people.
To address the shortfall, Abayomi said the state government is investing in its newly established University of Medicine and Health.
“Within five years, UMH will produce about 2,500 healthcare workers annually, including laboratory scientists and other essential cadres,” he stated.
The mass exodus of healthcare professionals popularly known as japa syndrome, especially doctors, nurses, and pharmacists has remained a major concern in Nigeria.
A 2017 survey conducted by a Nigerian polling organisation in partnership with Nigeria Health Watch revealed that about 88 per cent of Nigerian doctors were seeking job opportunities abroad at the time.
The President of the Nigerian Medical Association, Prof. Bala Audu, recently warned that Nigeria has moved beyond passive brain drain and has become a direct recruitment hub for foreign governments seeking skilled medical professionals.
In an interview, Audu revealed that international recruiters now visit Nigeria to directly hire doctors—particularly specialists such as obstetricians, gynaecologists, and paediatricians—offering them superior working conditions, remuneration, and infrastructure.
He lamented that while Nigeria’s population continues to grow and mortality rates remain high, the country is losing specialists at an alarming rate.
“Many of our doctors are not even going abroad to look for jobs. Foreign governments now come into Nigeria to pick doctors and take them away,” Audu said.
“We are still having more births, yet maternal deaths remain high because the skilled birth attendants who should care for these women are reducing every day.”
Audu added that in some specialties, the number of Nigerian doctors practising abroad may already exceed those still working within the country, a situation worsened by the government’s failure to significantly improve doctors’ welfare despite existing policy frameworks.
Experts have warned that with the current pace of emigration, it would be impossible for Nigeria to produce enough health workers to meet its growing healthcare demands. They estimate that it would take at least 20 years to train the over 400,000 health workers required to close the gap.
A former President of the NMA, Prof. Mike Ogirima, described Nigeria’s doctor-to-patient ratio as “horrible,” noting that the country currently has about one doctor to 8,000 patients—far below the World Health Organisation’s recommendation of one doctor to 600 patients.
Health
Neglect of routine self-breast examination, routine PSA test fueling cancer deaths

Nigerian health communication researcher, Ifesinachi Ayogu, has attributed the rising number of cancer-related deaths in the country to the neglect of routine self-breast examination among women and routine Prostate-Specific Antigen (PSA) testing among men.
Ayogu told journalists on Monday that the failure to prioritise regular screening had contributed significantly to late detection of breast and prostate cancers, which are among the leading causes of cancer-related deaths in Nigeria.
He said many cancer cases were only discovered when the disease had reached advanced stages, making treatment more complex and survival chances lower.
According to him, the increasing burden of cancer deaths calls for a more intentional and sustained approach to cancer awareness, early detection, and preventive health behaviour.
“Early detection saves lives, but many people are not practising simple, routine screening that could help detect cancer early,” Ayogu said.
He noted that breast cancer and prostate cancer were often manageable when detected early, but ignorance, fear, stigma, and limited awareness continued to discourage people from carrying out regular checks.
The researcher explained that self-breast examination allows women to notice unusual lumps or changes early, while routine PSA testing helps detect prostate abnormalities before symptoms become severe.
Ayogu said deaths resulting from breast and prostate cancers were often preventable, stressing that delayed diagnosis was a major factor contributing to high mortality rates.
He added that many Nigerians still lacked basic information on how to conduct self-breast examinations, when to go for PSA tests, and where to seek appropriate medical care.
The health communication researcher emphasised the need for community-based education, especially in rural areas, using trusted platforms such as churches, markets, women’s groups, and radio programmes to promote routine screening practices.
He also urged healthcare providers and public health institutions to intensify public education on cancer prevention and ensure that screening information was simple, accurate, and accessible.
Ayogu advised individuals with a family history of breast or prostate cancer to be particularly vigilant about routine screening and healthy lifestyle practices.
He stressed that promoting routine self-breast examination and PSA testing would play a critical role in reducing late presentation and improving cancer survival outcomes in Nigeria.
Ifeshinachi Ayogu is a PhD graduate student, at the University of Oklahoma United States of America, his core interest is cancer communication, according to him, he believes that the next breakthroughs in cancer care for Nigerian women and men will not come from medicine alone.
Health
Fresh Ebola outbreak: Nigeria tightens border control

The Federal Government said it had intensified monitoring and screening procedures at all points of entry in response to the ongoing outbreak of the Ebola Virus Disease in the Democratic Republic of Congo.
The Director of Port Health Services at the Federal Ministry of Health and Social Welfare, Dr Akpan Nse, disclosed this in an exclusive interview with Saturday PUNCH on Friday.
Nse also noted that additional staff had been employed to strengthen border surveillance in the country.
Health authorities in the Democratic Republic of Congo declared an outbreak of Ebola virus disease in Kasai Province, where 28 suspected cases and 16 deaths, including four health workers, had been reported as of September 5, 2025.
The outbreak comes at a time when much of Central and West Africa is grappling with overlapping health and humanitarian crises, including cholera, malnutrition, and population displacement.
The DRC’s last outbreak of Ebola virus disease occurred in the north-western Equateur Province in April 2022.
It was brought under control within three months.
In Kasai Province, previous Ebola outbreaks were reported in 2007 and 2008. Overall, the country has experienced 15 outbreaks since the disease was first identified in 1976.
Ebola virus disease is a rare but severe, often fatal illness in humans.
It is transmitted to people through close contact with the blood, secretions, organs, or other bodily fluids of infected animals such as fruit bats (believed to be the natural hosts). Human-to-human transmission occurs through direct contact with the blood or bodily fluids of an infected person, contaminated objects, or the body of someone who died from the disease.
In the ongoing outbreak, samples tested on September 3 at the National Institute of Biomedical Research in the capital, Kinshasa, confirmed that the cause was Ebola Zaire, a strain of the Ebola virus.
Dr Nse noted that although Nigeria was at risk of importing the virus due to high levels of international travel with the DRC, Port Health Services was on alert and had strengthened surveillance to prevent this.
He said, “We have intensified surveillance at all points of entry across the country—airports, land borders, and seaports. Every inbound traveller coming from Congo to Nigeria is thoroughly screened, and we collect their medical history through mandatory forms.
“We have also reactivated our portals. Every passenger on every flight coming to Nigeria from Congo is screened upon arrival. This applies to airports, seaports, and land borders. Even if passengers transit through Congo on their way to Nigeria, they must undergo screening.
“In addition, with support from WHO, we have recruited more staff to enhance surveillance. Increasing the workforce allows us to effectively prevent the importation of the virus and ensure thorough screening at all borders.”
He added that some private organisations had partnered the Federal Government to ensure that thermal scanners at airports remained fully functional.
Meanwhile, the WHO has released $500,000 from its Contingency Fund for Emergencies to support the response to the Ebola Virus Disease outbreak in the DR Congo.
Announcing this at a media briefing on global health issues on Friday, the WHO Director-General, Dr Tedros Adhanom Ghebreyesus, disclosed that 28 suspected cases and 16 deaths had been reported so far, including four health workers.
He highlighted that the UN body already had staff on the ground in Kasai, with more on the way.
“We’re joining rapid response teams to trace contacts and find cases; we’re collecting and testing samples, and we’re providing technical expertise in surveillance, infection prevention and control, treatment, risk communication, and more. WHO has also delivered personal protective equipment, laboratory equipment, medical supplies, and a mobile laboratory.
“We had previously prepositioned 2000 doses of Ebola vaccine in Kinshasa, which we are releasing to vaccinate contacts and health workers. This is the 16th outbreak of Ebola in the DRC, and the government has rich experience from those previous outbreaks,” the WHO boss stated.
Health
Meningitis kills 74 in Nigeria, 22 states affected – NCDC

The Nigeria Centre for Disease Control and Prevention says the country has recorded a total of 807 suspected cases of cerebrospinal meningitis, and 74 deaths from 22 states as of March 26, 2025
The NCDC stated that the Case Fatality Rate is at 9.2 per cent as of March 26, 2025.3.27
The centre disclosed this in a statement titled: “CSM outbreak: NCDC rapid response teams in Kebbi, Sokoto, and Katsina states,” signed by its Head of Corporate Communication, Sani Datti, on Thursday.
It said its Rapid Response Teams are already in Kebbi, Sokoto, and Katsina states in response to the ongoing outbreak of CSM.
It noted that the deployment follows a significant increase in suspected cases reported from these states.
“As of 26th March 2025, a total of 807 suspected cases and 74 deaths have been reported across 22 states, with a CFR of 9.2 per cent.
“Affected states include Kebbi, Katsina, Jigawa, Yobe, Gombe, Adamawa, Borno, Ebonyi, Oyo, Bauchi, Ondo, Kaduna, Osun, Akwa Ibom, Anambra, Bayelsa, Benue, Ekiti, Niger, Plateau, FCT, and Sokoto.
Idris emphasised the importance of personal safety and instructed all team members to strictly observe infection prevention and control protocols throughout the response effort.
“The deployed teams, comprising multisectoral and interdisciplinary experts—including specialists in case management and lumbar puncture techniques—are already in the affected states and working closely with the state health authorities to contain the outbreak and prevent further transmission.
“Key objectives of the response include rapid containment of the outbreak; strengthening case management and IPC measures; enhancing surveillance and sample collection; conducting risk communication and community engagement activities; and identifying the outbreak’s source and recommending appropriate public health actions.
“The NCDC remains committed to supporting state governments and partners to safeguard the health of Nigerians through timely and effective response to public health threats,” he stated.
Health
WHO Lauds Enugu’s Healthcare Innovations, Declares Engr. Beloved-Dan Anike Most Pro-Health Chair

The World Health Organization (WHO) has commended Enugu State for its outstanding leadership in advancing Universal Health Coverage (UHC), recognizing the Executive Chairman of Enugu East Local Government Area, Engr. Pst. Beloved-Dan Obi Anike, as the most Pro-Health Mayor in Enugu State.
This recognition came during the official flag-off of the Enugu East Health Insurance Scheme at the Enugu Type Two Primary Health Care Center in Emene. The WHO South-East Zonal Coordinator, Dr. Chukwumuanya Igboekwu, highlighted the initiative as a groundbreaking model, marking the first time a Local Government Chairman in Nigeria has committed substantial resources toward community-wide healthcare access.
Dr. Igboekwu emphasized that Enugu East’s proactive approach aligns with global best practices, strengthening health security and enhancing economic growth through a healthier workforce. He applauded Enugu State’s strategic healthcare reforms, positioning it as a front-runner in the drive for Universal Health Coverage.
In his remarks, Engr. Pst. Beloved-Dan Obi Anike revealed that the newly launched scheme will enroll 5,000 elderly residents—both indigenes and non-indigenes aged 60 and above—into the State Universal Health Coverage program. The initiative, set to run from April 1, 2025, to April 1, 2026, guarantees free healthcare services for these beneficiaries.
The Mayor expressed gratitude to the Executive Governor of Enugu State for spearheading a wave of disruptive innovations across multiple sectors, particularly in healthcare. He reaffirmed his administration’s commitment to aligning with the state government’s vision, stating, “When you have a Governor delivering over a thousand projects concurrently, you must take steps to keep up with his momentum.”
As part of this commitment, Engr. Anike disclosed that his administration has also commenced the construction of Type One Primary Healthcare Centers in Neke-Uno and Obinagu Nike communities, with approval secured for three additional centers across Enugu East LGA.
Dr. Ifeyinwa Ani-Osheku, Executive Secretary of the Enugu State Primary Health Care Development Agency, described the initiative as a monumental achievement, emphasizing its life-changing impact on the elderly population. Similarly, Dr. Edith Okolo, Executive Secretary of the Enugu State Health Insurance Scheme, hailed the project as a historic milestone, ensuring that 5,000 people in Enugu East LGA will receive free healthcare for an entire year.
The event also had in attendance notable dignitaries, including the Member Representing Enugu East Rural Constituency, Hon. Raymond Ugwu; the Honourable Commissioner for Water Resources, Dr. Felix Nnamani; Member 4 of the Enugu State Local Government Service Commission, Amb. Mrs. Amaka Nweke; the Chairman of the Nigerian Medical Association, Rotarian Dr. Sunday; the PDP Chairman in Enugu East LGA, Hon. Okey Igbokwe, among others.
These stakeholders echoed WHO’s commendation, applauding the Enugu State Government’s unwavering commitment to strengthening healthcare systems and improving access to quality medical services.
Enugu State’s healthcare innovations continue to set a precedent, reinforcing its reputation as a leader in Universal Health Coverage and community-centered healthcare policies.
-

 News22 hours ago
News22 hours ago“Go and Verify”: How Sunday Umeha Is Redefining Representation in Ezeagu/Udi
-

 Politics4 days ago
Politics4 days agoMass exodus: Obi, Kwankwaso exit rocks ADC, 18 lawmakers join NDC
-
News1 day ago
Chief Sir Paul Chukwuma Lays His Beloved Sister to Rest
-

 Politics2 days ago
Politics2 days agoAnambra Communities Boil As Group Carpets Traditional Rulers Over Zoning
-

 News3 days ago
News3 days agoEnugu, SSDO advance domestic resource mobilisation for climate responsive budgeting
-

 News5 days ago
News5 days agoEnugu Govt Disowns Group Accused of Defrauding Traditional Medicine Practitioners
-

 Politics4 days ago
Politics4 days ago2027: Akpabio Moves to Block Ex-Governors from Contesting for Senate President
-

 Crime3 days ago
Crime3 days agoAnambra Police Burst Gunmen Armoury in Orumba
